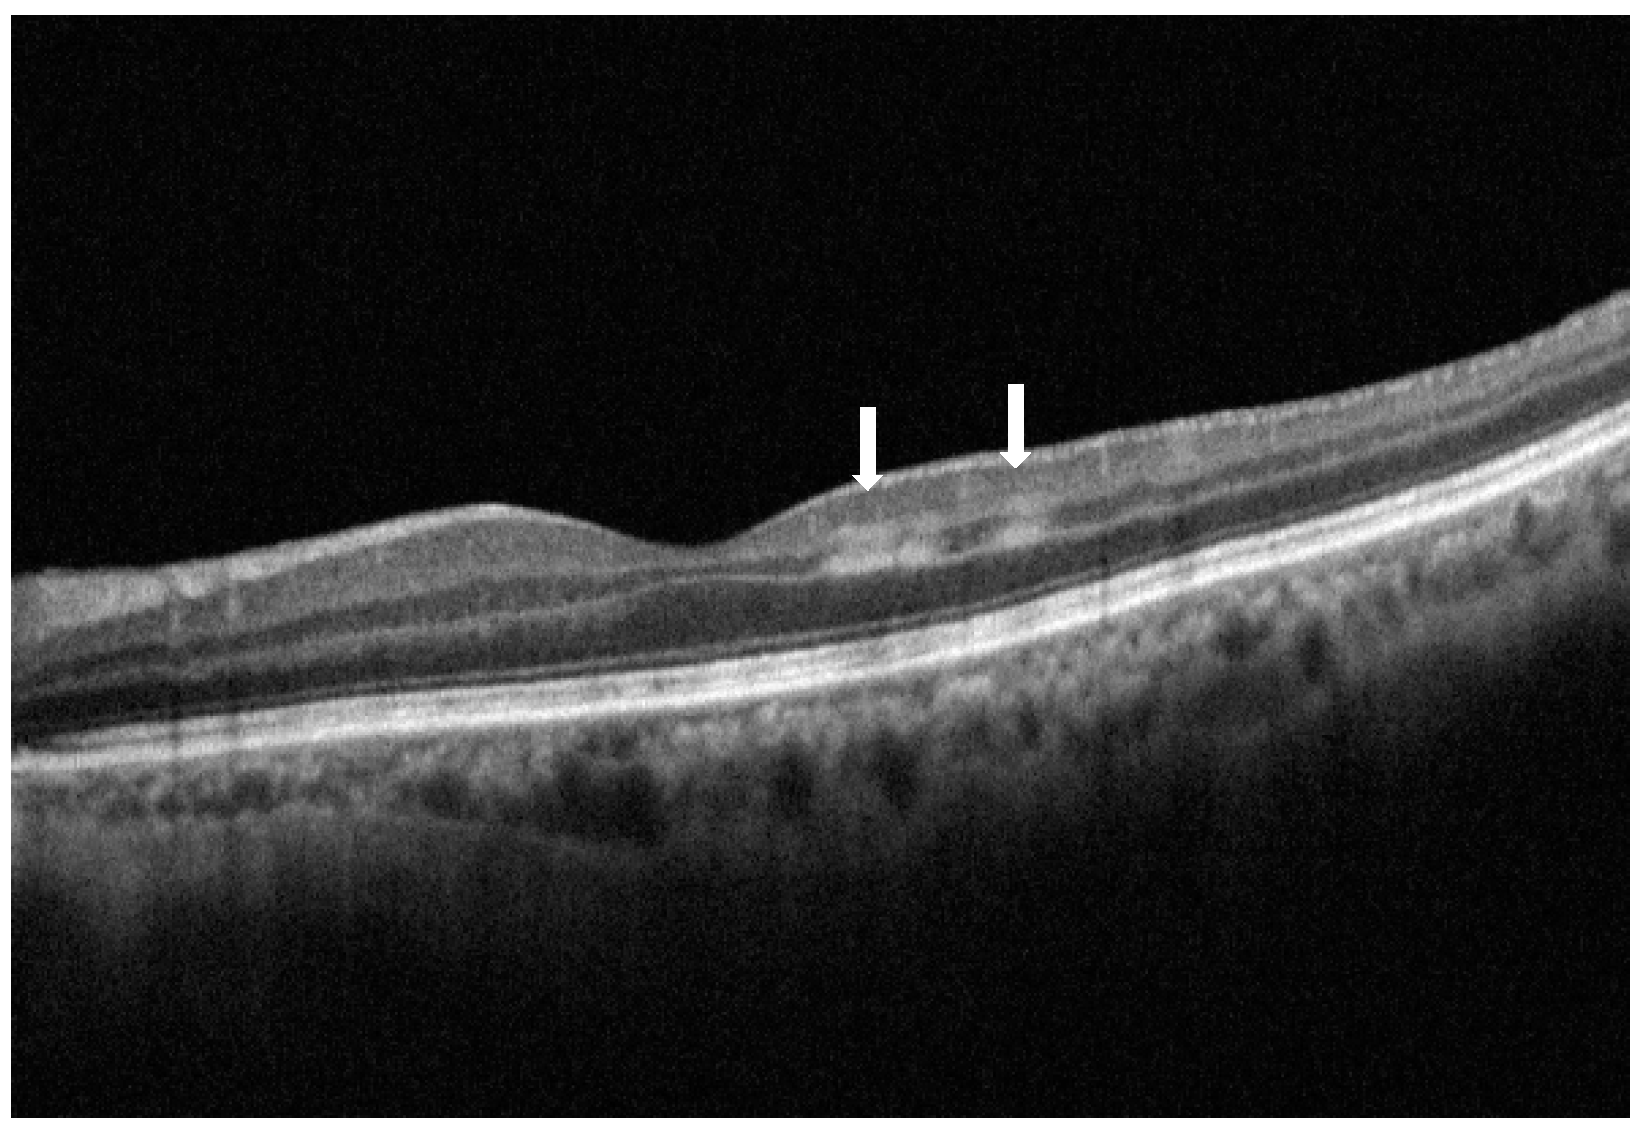
Vision 09 00019 g001
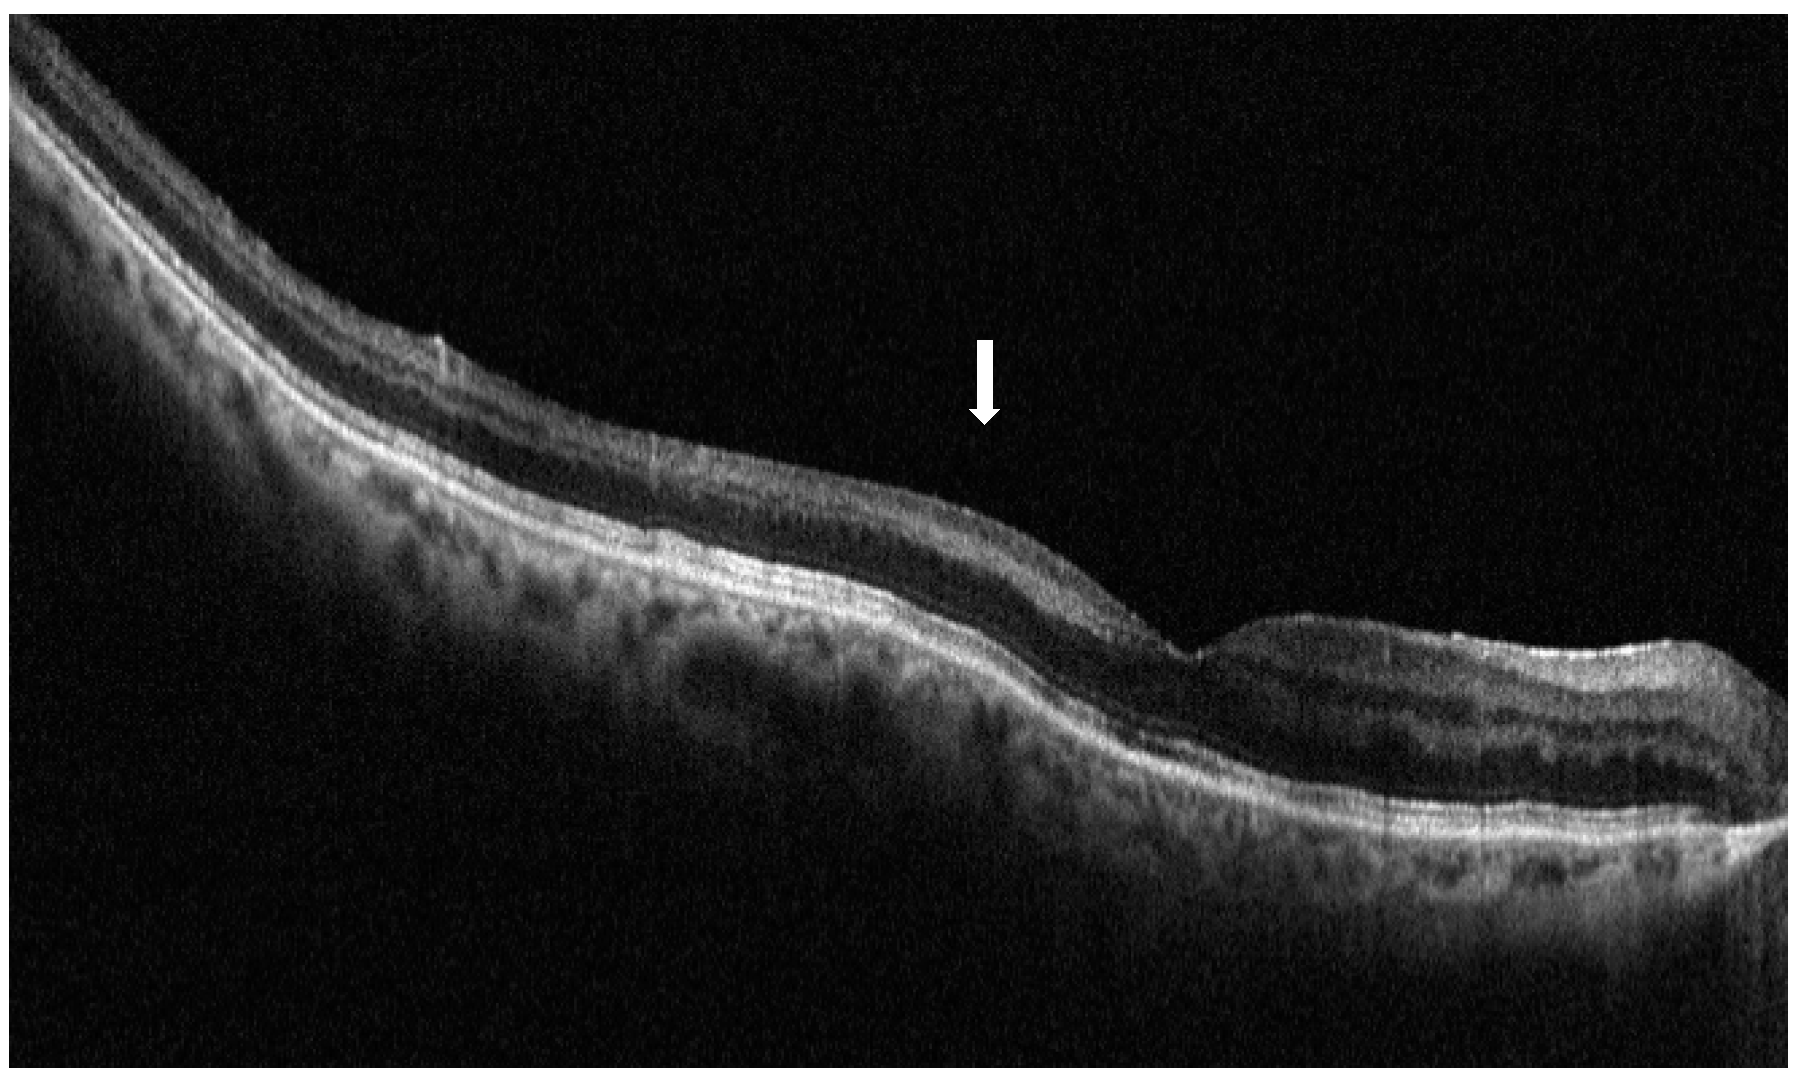
Vision 09 00019 g006

Paracentral Acute Middle Maculopathy (PAMM) in Ocular Vascular Diseases—What We Know and Future Perspectives
Abstract
1. Introduction
2. PAMM: Multimodal Imaging
3. PAMM: Clinical Findings
4. PAMM: Pathophysiology and Related Etiologies
5. PAMM in Arterial Insufficiency-Based Retinal Vascular Diseases
6. PAMM in Venous Impairment-Based Retinal Vascular Diseases
7. PAMM in Combined Vascular Deficiency-Based Retinal Vascular Diseases
7.1. Diabetic Retinopathy
7.2. Hypertensive Retinopathy
8. Conclusions and Future Perspectives
Author Contributions
Funding
Institutional Review Board Statement
Informed Consent Statement
Data Availability Statement
Acknowledgments
Conflicts of Interest
References
- McLeod, D. Misery Perfusion, Diffusive Oxygen Shunting and Interarterial Watershed Infarction Underlie Oxygenation-Based Hypoperfusion Maculopathy. Am. J. Ophthalmol. 2019, 205, 153–164. [Google Scholar] [CrossRef]
- Moura-Coelho, N.; Gaspar, T.; Ferreira, J.T.; Dutra-Medeiros, M.; Cunha, J.P. Paracentral Acute Middle Maculopathy—Review of the Literature. Graefes Arch. Clin. Exp. Ophthalmol. 2020, 258, 2583–2596. [Google Scholar] [CrossRef]
- Zhao, P.Y.; Johnson, M.W.; McDonald, H.R.; Sarraf, D. Paracentral Acute Middle Maculopathy and the Ischemic Cascade: Toward Interventional Management. Am. J. Ophthalmol. 2022, 234, 15–19. [Google Scholar] [CrossRef] [PubMed]
- Pichi, F.; Morara, M.; Veronese, C.; Lembo, A.; Nucci, P.; Ciardella, A.P. Perivenular Whitening in Central Vein Occlusion Described by Fundus Autofluorescence and Spectral Domain Optical Coherence Tomography. Retina 2012, 32, 1438–1439. [Google Scholar] [CrossRef] [PubMed]
- Paques, M.; Gaudric, A. Perivenular Macular Whitening During Acute Central Retinal Vein Occlusion. Arch. Ophthalmol. 2003, 121, 1488–1491. [Google Scholar] [CrossRef]
- Browning, D.J. Patchy Ischemic Retinal Whitening in Acute Central Retinal Vein Occlusion. Ophthalmology 2002, 109, 2154–2159. [Google Scholar] [CrossRef] [PubMed]
- Sarda, V.; Nakashima, K.; Wolff, B.; Sahel, J.-A.; Paques, M. Topography of Patchy Retinal Whitening during Acute Perfused Retinal Vein Occlusion by Optical Coherence Tomography and Adaptive Optics Fundus Imaging. Eur. J. Ophthalmol. 2011, 21, 653–656. [Google Scholar] [CrossRef]
- Sarraf, D.; Rahimy, E.; Fawzi, A.A.; Sohn, E.; Barbazetto, I.; Zacks, D.N.; Mittra, R.A.; Klancnik, J.M., Jr.; Mrejen, S.; Goldberg, N.R.; et al. Paracentral Acute Middle Maculopathy: A New Variant of Acute Macular Neuroretinopathy Associated With Retinal Capillary Ischemia. JAMA. Ophthalmol. 2013, 131, 1275–1287. [Google Scholar] [CrossRef]
- Scharf, J.; Freund, K.B.; Sadda, S.; Sarraf, D. Paracentral Acute Middle Maculopathy and the Organization of the Retinal Capillary Plexuses. Prog. Retin. Eye Res. 2021, 81, 100884. [Google Scholar] [CrossRef]
- Adhi, M.; Liu, J.J.; Qavi, A.H.; Grulkowski, I.; Lu, C.D.; Mohler, K.J.; Ferrara, D.; Kraus, M.F.; Baumal, C.R.; Witkin, A.J.; et al. Choroidal Analysis in Healthy Eyes Using Swept-Source Optical Coherence Tomography Compared to Spectral Domain Optical Coherence Tomography. Am. J. Ophthalmol. 2014, 157, 1272–1281.e1. [Google Scholar] [CrossRef]
- Di Pippo, M.; Santia, C.; Rullo, D.; Ciancimino, C.; Grassi, F.; Abdolrahimzadeh, S. The Choroidal Vascularity Index Versus Optical Coherence Tomography Angiography in the Evaluation of the Choroid with a Focus on Age-Related Macular Degeneration. Tomography 2023, 9, 1456–1470. [Google Scholar] [CrossRef] [PubMed]
- Maltsev, D.S.; Kulikov, A.N.; Burnasheva, M.A. Choriocapillaris Alteration in Patients with Paracentral Acute Middle Maculopathy. Eur. J. Ophthalmol. 2022, 32, 3622–3628. [Google Scholar] [CrossRef]
- Rahimy, E.; Sarraf, D. Paracentral Acute Middle Maculopathy Spectral-Domain Optical Coherence Tomography Feature of Deep Capillary Ischemia. Curr. Opin. Ophthalmol. 2014, 25, 207. [Google Scholar] [CrossRef]
- Lau, T.; Wong, I.Y.; Iu, L.; Chhablani, J.; Yong, T.; Hideki, K.; Lee, J.; Wong, R. En-Face Optical Coherence Tomography in the Diagnosis and Management of Age-Related Macular Degeneration and Polypoidal Choroidal Vasculopathy. Indian J. Ophthalmol. 2015, 63, 378–383. [Google Scholar] [CrossRef]
- Shah, A.; Rishi, P.; Chendilnathan, C.; Kumari, S. OCT Angiography Features of Paracentral Acute Middle Maculopathy. Indian J. Ophthalmol. 2019, 67, 417. [Google Scholar] [CrossRef] [PubMed]
- Burnasheva, M.A.; Maltsev, D.S.; Kulikov, A.N.; Sherbakova, K.A.; Barsukov, A.V. Association of Chronic Paracentral Acute Middle Maculopathy Lesions with Hypertension. Ophthalmol. Retin. 2020, 4, 504–509. [Google Scholar] [CrossRef] [PubMed]
- Long, C.P.; Chan, A.X.; Bakhoum, C.Y.; Toomey, C.B.; Madala, S.; Garg, A.K.; Freeman, W.R.; Goldbaum, M.H.; DeMaria, A.N.; Bakhoum, M.F. Prevalence of Subclinical Retinal Ischemia in Patients with Cardiovascular Disease—A Hypothesis Driven Study. EClinicalMedicine 2021, 33, 100775. [Google Scholar] [CrossRef]
- Maltsev, D.S.; Kulikov, A.N.; Burnasheva, M.A.; Chhablani, J. Prevalence of Resolved Paracentral Acute Middle Maculopathy Lesions in Fellow Eyes of Patients with Unilateral Retinal Vein Occlusion. Acta Ophthalmol. 2020, 98, e22–e28. [Google Scholar] [CrossRef]
- Waheed, N.K.; Rosen, R.B.; Jia, Y.; Munk, M.R.; Huang, D.; Fawzi, A.; Chong, V.; Nguyen, Q.D.; Sepah, Y.; Pearce, E. Optical Coherence Tomography Angiography in Diabetic Retinopathy. Prog. Retin. Eye Res. 2023, 97, 101206. [Google Scholar] [CrossRef]
- Abtahi, S.-H.; Nourinia, R.; Mazloumi, M.; Nouri, H.; Arevalo, J.F.; Ahmadieh, H. Retinal Ischemic Cascade: New Insights into the Pathophysiology and Imaging Findings. Surv. Ophthalmol. 2023, 68, 380–387. [Google Scholar] [CrossRef]
- Kaur, M.; Yip, K. The Current and Novel Imaging Modalities for Ocular Vasculitis in Behcet’s Disease: A Review. Cureus 2024, 16, e69528. [Google Scholar] [CrossRef] [PubMed]
- Spaide, R.F.; Fujimoto, J.G.; Waheed, N.K.; Sadda, S.R.; Staurenghi, G. Optical Coherence Tomography Angiography. Prog. Retin. Eye Res. 2018, 64, 888–893. [Google Scholar] [CrossRef] [PubMed]
- Casalino, G.; Williams, M.; McAvoy, C.; Bandello, F.; Chakravarthy, U. Optical Coherence Tomography Angiography in Paracentral Acute Middle Maculopathy Secondary to Central Retinal Vein Occlusion. Eye 2016, 30, 888–893. [Google Scholar] [CrossRef]
- Aribas, Y.K.; Aktas, Z.; Bayrakceken, K.; Atalay, T.; Ozdek, S. Paracentral acute middle maculopathy in primary congenital glaucoma. Retin. Cases Brief Rep. 2020, 14, 163. [Google Scholar] [CrossRef] [PubMed]
- Chen, Y.; Hu, Y. The Optical Imaging of Idiopathic Paracentral Acute Middle Maculopathy in a Chinese Young Man and Review of the Literature. Photodiagnosis Photodyn. Ther. 2017, 19, 383–387. [Google Scholar] [CrossRef]
- Phasukkijwatana, N.; Rahimi, M.; Iafe, N.; Sarraf, D. Central Retinal Vein Occlusion and Paracentral Acute Middle Maculopathy Diagnosed With En Face Optical Coherence Tomography. Ophthalmic Surg. Lasers Imaging Retin. 2016, 47, 862–864. [Google Scholar] [CrossRef]
- Kıyat, P.; Değirmenci, C.; Nalçacı, S.; Afrashi, F.; Akkın, C. Paracentral Acute Middle Maculopathy. Turk. J. Ophthalmol. 2020, 50, 193–196. [Google Scholar] [CrossRef]
- Chu, S.; Nesper, P.L.; Soetikno, B.T.; Bakri, S.J.; Fawzi, A.A. Projection-Resolved OCT Angiography of Microvascular Changes in Paracentral Acute Middle Maculopathy and Acute Macular Neuroretinopathy. Investig. Ophthalmol. Vis. Sci. 2018, 59, 2913–2922. [Google Scholar] [CrossRef]
- Elwood, K.F.; Wong, R.W. Paracentral acute middle maculopathy after preworkout havok ingestion. Retin. Cases Brief Rep. 2020. [Google Scholar] [CrossRef]
- Li, X.-Y.; Wang, S.; Dong, L.; Zhang, H. Comparison of Fundus Fluorescein Angiography and Fundus Photography Grading Criteria for Early Diabetic Retinopathy. Int. J. Ophthalmol. 2022, 15, 261–267. [Google Scholar] [CrossRef]
- Häner, N.U.; Dysli, C.; Munk, M.R. Imaging in Retinal Vascular Disease: A Review. Clin. Exp. Ophthalmol. 2023, 51, 217–228. [Google Scholar] [CrossRef] [PubMed]
- An, W.; Han, J. Research Progress of UWFFA and OCTA in Retinal Vein Occlusion: A Review. Eur. J. Ophthalmol. 2021, 31, 2850–2855. [Google Scholar] [CrossRef] [PubMed]
- Schmidt, D. A Fluorescein Angiographic Study of Branch Retinal Artery Occlusion (BRAO)—The Retrograde Filling of Occluded Vessels. Eur. J. Med. Res. 1999, 4, 491–506. [Google Scholar]
- Chen, X.; Rahimy, E.; Sergott, R.C.; Nunes, R.P.; Souza, E.C.; Choudhry, N.; Cutler, N.E.; Houston, S.K.S.; Munk, M.R.; Fawzi, A.A.; et al. Spectrum of Retinal Vascular Diseases Associated With Paracentral Acute Middle Maculopathy. Am. J. Ophthalmol. 2015, 160, 26–34.e1. [Google Scholar] [CrossRef]
- Dansingani, K.K.; Freund, K.B. Paracentral Acute Middle Maculopathy and Acute Macular Neuroretinopathy: Related and Distinct Entities. Am. J. Ophthalmol. 2015, 160, 1–3.e2. [Google Scholar] [CrossRef] [PubMed]
- Yung, M.; Klufas, M.A.; Sarraf, D. Clinical Applications of Fundus Autofluorescence in Retinal Disease. Int. J. Retin. Vitr. 2016, 2, 12. [Google Scholar] [CrossRef]
- Parodi, M.B.; Arrigo, A.; Rajabian, F.; Tecilazich, F.; Giustina, A.; Bandello, F.; Jampol, L.M. Paracentral acute middle maculopathy in central retinal vein occlusion complicating amyloid light-chain amyloidosis. Retin. Cases Brief Rep. 2022, 16, 543–546. [Google Scholar] [CrossRef]
- Bhavsar, K.V.; Lin, S.; Rahimy, E.; Joseph, A.; Freund, K.B.; Sarraf, D.; Cunningham, E.T. Acute Macular Neuroretinopathy: A Comprehensive Review of the Literature. Surv. Ophthalmol. 2016, 61, 538–565. [Google Scholar] [CrossRef] [PubMed]
- Tripathy, K.; Salini, B. Amsler Grid. In StatPearls; StatPearls Publishing: Treasure Island, FL, USA, 2024. [Google Scholar]
- Molina-Martín, A.; Pérez-Cambrodí, R.J.; Piñero, D.P. Current Clinical Application of Microperimetry: A Review. Semin. Ophthalmol. 2018, 33, 620–628. [Google Scholar] [CrossRef]
- Kılıç Müftüoğlu, İ.; Önder Tokuç, E.; Karabaş, V.L. Bilateral Sequential Paracentral Acute Middle Maculopathy. Turk. J. Ophthalmol. 2021, 51, 403–406. [Google Scholar] [CrossRef]
- Rahimy, E.; Kuehlewein, L.; Sadda, S.R.; Sarraf, D. Paracentral Acute Middle Maculopathy: What We Knew Then and What We Know Now. Retina 2015, 35, 1921. [Google Scholar] [CrossRef] [PubMed]
- Nakashima, H.; Iwama, Y.; Tanioka, K.; Emi, K. Paracentral Acute Middle Maculopathy Following Vitrectomy for Proliferative Diabetic Retinopathy: Incidence, Risk Factors, and Clinical Characteristics. Ophthalmology 2018, 125, 1929–1936. [Google Scholar] [CrossRef] [PubMed]
- Chandrasekera, E.; An, D.; McAllister, I.L.; Yu, D.-Y.; Balaratnasingam, C. Three-Dimensional Microscopy Demonstrates Series and Parallel Organization of Human Peripapillary Capillary Plexuses. Investig. Ophthalmol. Vis. Sci. 2018, 59, 4327–4344. [Google Scholar] [CrossRef]
- Hogan, M.J.; Feeney, L. The ultrastructure of the retinal blood vessels. I. The large vessels. J. Ultrastruct. Res. 1963, 39, 10–28. [Google Scholar] [CrossRef] [PubMed]
- Hogan, M.J.; Feeney, L. The ultrastructure of the retinal vessels. ii. The small vessels. J. Ultrastruct. Res. 1963, 49, 29–46. [Google Scholar] [CrossRef]
- An, D.; Yu, P.; Freund, K.B.; Yu, D.-Y.; Balaratnasingam, C. Three-Dimensional Characterization of the Normal Human Parafoveal Microvasculature Using Structural Criteria and High-Resolution Confocal Microscopy. Investig. Ophthalmol. Vis. Sci. 2020, 61, 3. [Google Scholar] [CrossRef] [PubMed]
- Iovino, C.; Au, A.; Ramtohul, P.; Bacci, T.; AlBahlal, A.; Khan, A.M.; Al-Abdullah, A.A.; Wendel, R.; Chhablani, J.; Sadda, S.; et al. Coincident PAMM and AMN and Insights Into a Common Pathophysiology. Am. J. Ophthalmol. 2022, 236, 136–146. [Google Scholar] [CrossRef]
- Yu, D.Y.; Cringle, S.J. Oxygen Distribution and Consumption within the Retina in Vascularised and Avascular Retinas and in Animal Models of Retinal Disease. Prog. Retin. Eye Res. 2001, 20, 175–208. [Google Scholar] [CrossRef]
- Linsenmeier, R.A.; Zhang, H.F. Retinal Oxygen: From Animals to Humans. Prog. Retin. Eye. Res. 2017, 58, 115–151. [Google Scholar] [CrossRef]
- McLeod, D.; Beatty, S. Evidence for an Enduring Ischaemic Penumbra Following Central Retinal Artery Occlusion, with Implications for Fibrinolytic Therapy. Prog. Retin. Eye Res. 2015, 49, 82–119. [Google Scholar] [CrossRef]
- Bousquet, E.; Santina, A.; Sarraf, D. Chapter 17—Paracentral Acute Middle Maculopathy and Acute Macular Neuroretinopathy: Distinct but Related Entities. In Retinal and Choroidal Vascular Diseases of the Eye; Chhablani, J., Ed.; Academic Press: Cambridge, MA, USA, 2024; pp. 249–258. ISBN 978-0-443-15583-3. [Google Scholar]
- Bakhoum, M.F.; Freund, K.B.; Dolz-Marco, R.; Leong, B.C.S.; Baumal, C.R.; Duker, J.S.; Sarraf, D. Paracentral Acute Middle Maculopathy and the Ischemic Cascade Associated With Retinal Vascular Occlusion. Am. J. Ophthalmol. 2018, 195, 143–153. [Google Scholar] [CrossRef] [PubMed]
- Falavarjani, K.G.; Phasukkijwatana, N.; Freund, K.B.; Cunningham, E.T.; Kalevar, A.; McDonald, H.R.; Dolz-Marco, R.; Roberts, P.K.; Tsui, I.; Rosen, R.; et al. En Face Optical Coherence Tomography Analysis to Assess the Spectrum of Perivenular Ischemia and Paracentral Acute Middle Maculopathy in Retinal Vein Occlusion. Am. J. Ophthalmol. 2017, 177, 131–138. [Google Scholar] [CrossRef]
- Michalak, S.M.; Mukherjee, N.; Gospe, S.M.I. Bilateral paracentral acute middle maculopathy after cardiopulmonary bypass. Retin. Cases Brief Rep. 2022, 16, 285. [Google Scholar] [CrossRef]
- Garrity, S.T.; Tseng, V.L.; Sarraf, D. Paracentral acute middle maculopathy in a perivenular fern-like distribution with en face optical coherence tomography. Retin. Cases Brief Rep. 2018, 12, S25. [Google Scholar] [CrossRef]
- Akhavanrezayat, A.; Hien, D.L.; Pham, B.H.; Nguyen, H.V.; Tuong Ngoc, T.T.; Al-Moujahed, A.; Uludag, G.; Karkhur, S.; Doan, H.L.; Nguyen, Q.D. Impending Central Retinal Vein Occlusion in Patient with Idiopathic Cutaneous Leukocytoclastic Vasculitis. Am. J. Ophthalmol. Case Rep. 2020, 20, 100934. [Google Scholar] [CrossRef] [PubMed]
- Turedi, N.; Onal Gunay, B. Paracentral Acute Middle Maculopathy in the Setting of Central Retinal Artery Occlusion Following COVID-19 Diagnosis. Eur. J. Ophthalmol. 2022, 32, NP62–NP66. [Google Scholar] [CrossRef] [PubMed]
- Christenbury, J.G.; Klufas, M.A.; Sauer, T.C.; Sarraf, D. OCT Angiography of Paracentral Acute Middle Maculopathy Associated With Central Retinal Artery Occlusion and Deep Capillary Ischemia. Ophthalmic Surg. Lasers Imaging Retin. 2015, 46, 579–581. [Google Scholar] [CrossRef]
- Ozsaygılı, C.; Bayram, N.; Ozdemir, H. Cilioretinal Artery Occlusion with Paracentral Acute Middle Maculopathy Associated with COVID-19. Indian J. Ophthalmol. 2021, 69, 1956. [Google Scholar] [CrossRef]
- Pichi, F.; Fragiotta, S.; Freund, K.B.; Au, A.; Lembo, A.; Nucci, P.; Sebastiani, S.; Gutierrez Hernandez, J.C.; Interlandi, E.; Pellegrini, F.; et al. Cilioretinal Artery Hypoperfusion and Its Association with Paracentral Acute Middle Maculopathy. Br. J. Ophthalmol. 2019, 103, 1137–1145. [Google Scholar] [CrossRef]
- Baciu, P.; Nofar, C.M.; Spaulding, J.; Gao, H. Branch retinal artery occlusion associated with paracentral acute middle maculopathy in a patient with livedo reticularis. Retin. Cases Brief Rep. 2017, 11, 356. [Google Scholar] [CrossRef]
- Ong, S.S.; Ahmed, I.; Scott, A.W. Association of Acute Macular Neuroretinopathy or Paracentral Acute Middle Maculopathy with Sickle Cell Disease. Ophthalmol. Retin. 2021, 5, 1146–1155. [Google Scholar] [CrossRef]
- Sellam, A.; Glacet-Bernard, A.; Coscas, F.; Souied, E.H. Trouble de La Perfusion Artérielle Rétinienne et Tomographie En Cohérence Optique-Angiographie. J. Français D ophtalmol. 2017, 40, 353–362. [Google Scholar] [CrossRef]
- Sridhar, J.; Shahlaee, A.; Shieh, W.-S.; Rahimy, E. Paracentral Acute Middle Maculopathy Associated with Retinal Artery Occlusion after Cosmetic Filler Injection. Retin. Cases Brief Rep. 2017, 11, S216–S218. [Google Scholar] [CrossRef]
- Iafe, N.A.; Onclinx, T.; Tsui, I.; Sarraf, D. Paracentral Acute Middle Maculopathy and Deep Retinal Capillary Plexus Infarction Secondary to Reperfused Central Retinal Artery Occlusion. Retin. Cases Brief Rep. 2017, 11, S90–S93. [Google Scholar] [CrossRef]
- Maltsev, D.S.; Kulikov, A.N.; Burnasheva, M.A. Association of Resolved Paracentral Acute Middle Maculopathy Lesions with Diabetic Retinopathy. J. Curr. Ophthalmol. 2022, 34, 318–322. [Google Scholar] [CrossRef]
- Wang, D.; Au, A.; Duker, J.S.; Sarraf, D. PAMM and the Ischemic Cascade Associated with Radiation Retinopathy. Am. J. Ophthalmol. Case Rep. 2020, 20, 100918. [Google Scholar] [CrossRef]
- Paracentral Acute Middle Maculopathy in Sickle Cell Disease|Hematology|JAMA Ophthalmology|JAMA Network. Available online: https://jamanetwork.com/journals/jamaophthalmology/article-abstract/2119071 (accessed on 9 September 2024).
- Creese, K.; Ong, D.; Sandhu, S.S.; Ware, D.; Alex Harper, C.; Al-Qureshi, S.H.; Wickremasinghe, S.S. Paracentral Acute Middle Maculopathy as a Finding in Patients with Severe Vision Loss Following Phacoemulsification Cataract Surgery. Clin. Exp. Ophthalmol. 2017, 45, 598–605. [Google Scholar] [CrossRef]
- Paracentral Acute Middle Maculopathy in a Young Patient Following Routine Phacoemulsification Surgery–Pham–2019—Clinical & Experimental Ophthalmology—Wiley Online Library. Available online: https://onlinelibrary.wiley.com/doi/10.1111/ceo.13597 (accessed on 9 September 2024).
- Paracentral Acute Middle Maculopathy Associated with Severe Vision Loss Following Vitrectomy for Vitreous Haemorrhage–Hooshmand–2018—Clinical & Experimental Ophthalmology—Wiley Online Library. Available online: https://onlinelibrary.wiley.com/doi/10.1111/ceo.13151 (accessed on 9 September 2024).
- Stavrakas, P.; Karmiris, E.; Tranos, P.; Ananikas, K.; Tooulias, C.; Rouvas, A.; Androu, A. Paracentral Acute Middle Maculopathy Following Surgically Induced Branch Retinal Artery Occlusion During Vitrectomy. Case Rep. Ophthalmol. 2021, 12, 25–31. [Google Scholar] [CrossRef]
- Ang, M.J.; Chen, J.J.; McDonald, H.R. Paracentral acute middle maculopathy after epiretinal membrane removal. Retin. Cases Brief Rep. 2021, 15, 647. [Google Scholar] [CrossRef] [PubMed]
- Henein, W.; Wilson-Pogmore, A.; Imrie, F. A Unique Case of Paracentral Acute Middle Maculopathy with Associated Cystoid Macular Oedema Post Uncomplicated Pterygium Surgery. Am. J. Ophthalmol. Case Rep. 2020, 20, 100925. [Google Scholar] [CrossRef] [PubMed]
- O’Day, R.; Harper, C.A.; Wickremasinghe, S.S. Central Retinal Artery Occlusion Showing Features of Paracentral Acute Middle Maculopathy Following Uncomplicated Pterygium Surgery. Clin. Exp. Ophthalmol. 2019, 47, 141–143. [Google Scholar] [CrossRef] [PubMed]
- Liu, J.; Korban, S.; Moster, M.R.; Rhéaume, M.-A.; Wang, Q. Bilateral Severe Iatrogenic Pigmentary Glaucoma Following Laser Treatment for Cosmetic Iris Color Change. Am. J. Ophthalmol. Case Rep. 2023, 32, 101927. [Google Scholar] [CrossRef] [PubMed]
- Xiao, H.; Guo, N.; Li, J.; Jin, L.; Liu, Y.; Lin, S.; Fang, L.; Liu, X.; Zuo, C. Paracentral Acute Middle Maculopathy Following Acute Primary Angle Closure and Acute Primary Angle Closure Glaucoma. Clin. Ophthalmol. 2023, 17, 3513–3523. [Google Scholar] [CrossRef]
- Mairot, K.; Gascon, P.; Stolowy, N.; Comet, A.; Attia, R.; Beylerian, M.; Granel, B.; Jarrot, P.-A.; Cohen, D.J.; Guez, G.; et al. Paracentral Acute Middle Maculopathy as a Specific Sign of Arteritic Anterior Ischemic Optic Neuropathy. Am. J. Ophthalmol. 2023, 248, 1–7. [Google Scholar] [CrossRef]
- Fernandes, R.D.; de Souza Andrade, T.; Preti, R.C.; Zacharias, L.C.; Silva, G.D.; Lucato, L.T.; Apóstolos-Pereira, S.L.; Callegaro, D.; Monteiro, M.L.R. Paracentral Acute Middle Maculopathy Associated with Severe Anti-Mog (Myelin Oligodendrocyte Glycoprotein)-Positive Optic Neuritis. Neuroophthalmology 2023, 47, 156–163. [Google Scholar] [CrossRef] [PubMed]
- Heroor, A.; Tyagi, M.; Kekunnaya, R.; Chattannavar, G. Paracentral Acute Middle Maculopathy in a Patient with Myelin Oligodendrocyte Glycoprotein Antibody Associated Optic Neuritis. Am. J. Ophthalmol. Case Rep. 2024, 34, 102058. [Google Scholar] [CrossRef] [PubMed]
- Ramtohul, P.; Freund, K.B. Central Acute Middle Maculopathy: A Novel Variant of Paracentral Acute Middle Maculopathy in Foveal Hypoplasia. Ophthalmol. Retin. 2020, 4, 344–347. [Google Scholar] [CrossRef]
- Samanta, R.; Dogra, M.; Puthalath, A.S.; Sood, G. Paracentral Acute Middle Maculopathy with Occlusive Retinal Vasculitis in Presumed Intraocular Tuberculosis and Hyperhomocysteinemia. BMJ Case Rep. 2022, 15, e249327. [Google Scholar] [CrossRef]
- Govindaraj, I.; Kuriakose, A.; Rajendran, A. Enlarging Aneurysm with Paracentral Acute Middle Maculopathy in Idiopathic Retinal Vasculitis, Aneurysms and Neuroretinitis (IRVAN)—A Case Report. Eur. J. Ophthalmol. 2024, 34, NP70–NP74. [Google Scholar] [CrossRef]
- Kanakis, M.; Georgalas, I.; Kozobolis, V.; Lekkou, A.; Karmiris, E.; Stavrakas, P. Late PAMM-Like Lesions in a Patient with HIV Retinopathy. Case Rep. Ophthalmol. 2023, 14, 23–28. [Google Scholar] [CrossRef]
- Grewal, D.S.; Polascik, B.A.; Kelly, M.P.; Fekrat, S. Widefield En Face Optical Coherence Tomography to Quantify the Extent of Paracentral Acute Middle Maculopathy. Can. J. Ophthalmol. 2017, 52, e85–e88. [Google Scholar] [CrossRef]
- Antaki, F.; Milad, D.; Hamel, T. Acute Retinal Ischaemia Associated with Paracentral Acute Middle Maculopathy Detected on Multimodal Imaging: A Premonitory Sign of Severe Carotid Occlusive Disease. BMJ Case Rep. 2022, 15, e252266. [Google Scholar] [CrossRef] [PubMed]
- Mishra, P.; Mohanty, S.; Shanmugasundaram, P.; Moharana, B.; Das, D. Paracentral Acute Middle Maculopathy As the Presenting Sign of Ischemic Cardiomyopathy. Cureus 2023, 15, e35418. [Google Scholar] [CrossRef]
- Cohen, M.N.; Dang, S.; Liang, M.C. Paracentral Acute Middle Maculopathy After Cardiac Arrest. Ophthalmology 2017, 124, 511. [Google Scholar] [CrossRef]
- Ilginis, T.; Keane, P.A.; Tufail, A. Paracentral Acute Middle Maculopathy in Sickle Cell Disease. JAMA Ophthalmol. 2015, 133, 614–616. [Google Scholar] [CrossRef] [PubMed]
- Koçak, N.; Erduran, B.; Subaşı, M.; Yeter, V. Paracentral acute middle maculopathy associated with branch retinal artery occlusion due to polycythemia in a patient with tetralogy of fallot. Retin. Cases Brief Rep. 2022, 16, 558. [Google Scholar] [CrossRef]
- Gulyesil, F.F.; Dogan, M.; Sabaner, M.C.; Gobeka, H.H.; Demirbas, H.; Sap Kinar, A.K. Paracentral Acute Middle Maculopathy Revealing a Giant Aortic Aneurysm. Ocul. Immunol. Inflamm. 2022, 30, 2000–2004. [Google Scholar] [CrossRef] [PubMed]
- Mine, I.; Taguchi, M.; Sakurai, Y.; Takeuchi, M. Bilateral Idiopathic Retinal Vasculitis Following Coxsackievirus A4 Infection: A Case Report. BMC Ophthalmol. 2017, 17, 128. [Google Scholar] [CrossRef]
- Driouich, Z.; Palmieri, F.; Hasan Gad Ali, A.; Younis, S. Early Presentation of COVID-19 Related Paracentral Acute Middle Maculopathy in a Healthy Young Patient. J. Fr. Ophtalmol. 2024, 47, 104121. [Google Scholar] [CrossRef]
- Premi, E.; Acampora, R.; Salmi, D.; Ilie, I.; Pagnoncelli, N.; Germano, F.; Gandolfi, G.; Sanicas, M.; Seed, A.; Michael, B.; et al. Clinical and Diagnostic Findings of Acute Macular Neuroretinopathy and Paracentral Acute Middle Maculopathy in the COVID-19 Era. Ophthalmologica 2023, 246, 181–191. [Google Scholar] [CrossRef]
- Gameiro Filho, A.R.; Godoy, R.; Rees, A.; Esposti, S.D. Paracentral acute middle maculopathy following COVID-19. Arq Bras Oftalmol. 2023, 86, 397–399. [Google Scholar] [CrossRef] [PubMed]
- Dutta Majumder, P.; Agarwal, A. Acute Macular Neuroretinopathy and Paracentral Acute Middle Maculopathy during SARS-CoV-2 Infection and Vaccination. Vaccines 2023, 11, 474. [Google Scholar] [CrossRef]
- Niyousha, M.R.; Hassanpoor, N.; Eftekhari, A.; Mousvi, F. Simultaneous Paracentral Acute Middle Maculopathy and Purtscher-like Retinopathy after Acute Febrile Illness. Can. J. Ophthalmol. 2018, 53, e184–e186. [Google Scholar] [CrossRef]
- Shahlaee, A.; Sridhar, J.; Rahimy, E.; Shieh, W.S.; Ho, A.C. Paracentral acute middle maculopathy associated with postviral purtscher-like retinopathy. Retin. Cases Brief Rep. 2019, 13, 50. [Google Scholar] [CrossRef]
- Zhao, B.; Yan, Y. Retinal Ischemia as a Presenting Ocular Sign of Neurofibromatosis Type 2. Case Rep. Ophthalmol. Med. 2024, 2024, 9133929. [Google Scholar] [CrossRef] [PubMed]
- Pellegrini, F.; Mairot, K.; Cuna, A.; Lee, A.G. Paracentral acute middle maculopathy in giant cell arteritis. Retin. Cases Brief Rep. 2024, 18, 285–289. [Google Scholar] [CrossRef] [PubMed]
- Boynes, A.C.; Gin, T.J.; Gin, T. Paracentral acute middle maculopathy associated with eosinophilic granulomatosis with polyangiitis. Retin. Cases Brief Rep. 2024, 18, 290–292. [Google Scholar] [CrossRef]
- Retinal Manifestations of Juvenile Dermatomyositis: Case Report of Bilateral Diffuse Chorioretinopathy with Paracentral Acute Middle Maculopathy and Review of the Literature: Ocular Immunology and Inflammation: Vol 26, No 6—Get Access. Available online: https://www.tandfonline.com/doi/full/10.1080/09273948.2017.1305421 (accessed on 9 September 2024).
- Starr, M.R.; Softing Hataye, A.L.; Bakri, S.J. Asymptomatic multifocal paracentral acute middle maculopathy associated with juvenile dermatomyositis: Optical coherence angiography findings. Retin. Cases Brief Rep. 2021, 15, 500. [Google Scholar] [CrossRef]
- Haider, A.S.; Viswanathan, D.; Williams, D.; Davies, P. Paracentral acute middle maculopathy in susac syndrome. Retin. Cases Brief Rep. 2020, 14, 150. [Google Scholar] [CrossRef]
- Neto, T.S.; Neto, E.D.; Balbi, G.G.; Signorelli, F.; Higashi, A.H.; Monteiro, M.L.R.; Bonfá, E.; Zacharias, L.C.; Andrade, D.C. Ocular Findings in Asymptomatic Patients with Primary Antiphospholipid Syndrome. Lupus 2022, 31, 1800–1807. [Google Scholar] [CrossRef]
- Takai, Y.; Inoue, K. A Case of Impending Central Retinal Vein Occlusion Associated With Antiphospholipid Antibody Syndrome Complicated by Paracentral Acute Intermediate Layer Maculopathy. Cureus 2023, 15, e37256. [Google Scholar] [CrossRef] [PubMed]
- Paracentral Acute Middle Maculopathy (PAMM) Associated with Ulcerative Colitis and Coexisting Hyperhomocysteinemia: A Case Report—Micol Alkabes, Stela Vujosevic, Andrea Muraca, Stefano De Cillà, 2022. Available online: https://journals.sagepub.com/doi/10.1177/1120672120962042 (accessed on 9 September 2024).
- Hall, M.N.; Maleki, A. Paracentral Acute Middle Maculopathy and Cotton Wool Spots in a Patient with Ocular Migraine: A Case Report. Eur. J. Ophthalmol. 2024, 34, 11206721241246583. [Google Scholar] [CrossRef]
- Milad, D.; Antaki, F.; Farah, A.; Hammamji, K.; Saab, M. Paracentral Acute Middle Maculopathy in Migraines with Aura. Case Rep. Ophthalmol. 2023, 14, 591–595. [Google Scholar] [CrossRef]
- Nagiel, A.; Lalane, R.A.; Jen, J.C.; Kreiger, A.E. Superficial and deep capillary ischemia as a presenting sign of retinal vasculopathy with cerebral leukoencephalopathy and systemic manifestations. Retin. Cases Brief Rep. 2018, 12, S87. [Google Scholar] [CrossRef]
- Denny, M.R.; Kalevar, A.; Chen, J.J.; Johnson, R.N. Paracentral acute middle maculopathy associated with idiopathic intracranial hypertension. Retin. Cases Brief Rep. 2021, 15, 540. [Google Scholar] [CrossRef] [PubMed]
- Zhao, Z.; Faith, P.; Pakzad-Vaezi, K.; Chu, Z.; Wang, R.K.; Mudumbai, R.C.; Rezaei, K.A. Paracentral acute middle maculopathy associated with bilateral optic disk swelling and meningitis. Retin. Cases Brief Rep. 2020, 14, 157. [Google Scholar] [CrossRef]
- Khatibi, A.; Nybo Andersen, A.-M.; Gissler, M.; Morken, N.-H.; Jacobsson, B. Obstetric and Neonatal Outcome in Women Aged 50 Years and up: A Collaborative, Nordic Population-Based Study. Eur. J. Obstet. Gynecol. Reprod. Biol. 2018, 224, 17–20. [Google Scholar] [CrossRef]
- Rivera-De La Parra, D.; Fromow-Guerra, J. Paracentral acute middle maculopathy in purtscher retinopathy. Retin. Cases Brief Rep. 2020, 14, 275. [Google Scholar] [CrossRef] [PubMed]
- Tokimitsu, M.; Murata, M.; Toriyama, Y.; Hirano, T.; Iesato, Y.; Murata, T. Delineation of Capillary Dropout in the Deep Retinal Capillary Plexus Using Optical Coherence Tomography Angiography in a Patient with Purtscher’s Retinopathy Exhibiting Normal Fluorescein Angiography Findings: A Case Report. BMC Ophthalmol. 2016, 16. [Google Scholar] [CrossRef]
- Goel, N.; D’ Souza, Z.; Tripathi, A.; Dey, A.; Sen, A.; Majumdar, B.; Thounaojam, S.; Roy, R.; Saurabh, K. Concomitant Paracentral Acute Middle Maculopathy and Acute Macular Neuroretinopathy in Eyes Post-Blunt Trauma. Indian J. Ophthalmol. 2023, 71, 2789–2795. [Google Scholar] [CrossRef]
- Lando, L.; Isaac, D.L.C.; Avila, M.P. Paracentral acute middle maculopathy after aortic aneurysm repair. Retin. Cases Brief Rep. 2022, 16, 177. [Google Scholar] [CrossRef] [PubMed]
- Khan, M.A.; Rahimy, E.; Shahlaee, A.; Hsu, J.; Ho, A.C. En Face Optical Coherence Tomography Imaging of Deep Capillary Plexus Abnormalities in Paracentral Acute Middle Maculopathy. Ophthalmic Surg. Lasers Imaging Retin. 2015, 46, 972–975. [Google Scholar] [CrossRef] [PubMed]
- Echegaray, J.J.; Echegaray, P.M.; Townsend-Pico, W. Penile Filler Injection Leading to Silicone Embolism Syndrome and Paracentral Acute Middle Maculopathy. Ophthalmic Surg. Lasers Imaging Retin. 2022, 53, 635–638. [Google Scholar] [CrossRef] [PubMed]
- Pee, X.K.; Low, A.; Ab Kahar, M.E.P.I.; Mohamed, S.O.; Chong, Y.-J. Purtscher-like Retinopathy and Paracentral Acute Middle Maculopathy Following Breast Filler Injection. BMC Ophthalmol. 2023, 23, 444. [Google Scholar] [CrossRef]
- Al-khersan, H.; Russell, J.F.; Shi, Y.; Sridhar, J.; Gregori, G.; Flynn, H.W.; Rosenfeld, P.J. Wide Field Swept Source OCT Angiography of Multifocal Retinal and Choroidal Occlusions from Embolic Triamcinolone Acetonide. Am. J. Ophthalmol. Case Rep. 2020, 18, 100704. [Google Scholar] [CrossRef]
- Meyerovitz, C.; Colwell, L.; Jeng-Miller, K. Paracentral Acute Middle Maculopathy Immediately Following Internal Carotid Endovascular Repair. Digit. J. Ophthalmol. 2023, 29, 58–60. [Google Scholar] [CrossRef]
- Schofield, J.R.; Palestine, A.G.; Pelak, V.; Mathias, M.T. Deep Capillary Retinal Ischemia and High-Titer Prothrombin-Associated Antiphospholipid Antibodies: A Case Series of Three Patients. Am. J. Ophthalmol. Case Rep. 2019, 14, 105–109. [Google Scholar] [CrossRef]
- Sebastiani, S.; Pellegrini, M.; Giannaccare, G.; Sarraf, D. Paracentral acute middle maculopathy associated with phosphodiesterase-5 inhibitor therapy. Retin. Cases Brief Rep. 2021, 15, 519. [Google Scholar] [CrossRef] [PubMed]
- Narala, R.; Reddy, S.A.; Mruthyunjaya, P. Giant Cell Arteritis Manifesting as Retinal Arterial Occlusion and Paracentral Acute Middle Maculopathy in a Patient on Pembrolizumab for Metastatic Uveal Melanoma. Am. J. Ophthalmol. Case Rep. 2020, 20, 100891. [Google Scholar] [CrossRef]
- Zonnevylle, K.E.; Jacob, J.; Luyten, S.; Stanescu-Segall, D. Paracentral acute middle maculopathy following oral intake of sumatriptan. Retin. Cases Brief Rep. 2022, 16, 180. [Google Scholar] [CrossRef]
- Juncal, V.R.; Bansal, A.; Hamli, H.; Muni, R.H. Paracentral Acute Middle Maculopathy Following Hepatitis B Vaccine. Am. J. Ophthalmol. Case Rep. 2022, 25, 101422. [Google Scholar] [CrossRef] [PubMed]
- Dehghani, A.; Ghanbari, H.; Houshang-Jahromi, M.; Pourazizi, M. Paracentral Acute Middle Maculopathy and COVID-19 Vaccination: Causation versus Coincidence Finding. Clin. Case Rep. 2022, 10, e05578. [Google Scholar] [CrossRef] [PubMed]
- Scott, R.A.; Bhat, N.; Bindiganavile, S.H.; Li, H.K.; Lee, A.G. Paracentral Acute Middle Maculopathy in Pregnancy. J. Neuroophthalmol. 2022, 42, e440–e442. [Google Scholar] [CrossRef] [PubMed]
- Park, S.J.; Choi, N.-K.; Yang, B.R.; Park, K.H.; Lee, J.; Jung, S.-Y.; Woo, S.J. Risk and Risk Periods for Stroke and Acute Myocardial Infarction in Patients with Central Retinal Artery Occlusion. Ophthalmology 2015, 122, 2336–2343.e2. [Google Scholar] [CrossRef]
- Hayreh, S.S. Central Retinal Artery Occlusion. Indian J. Ophthalmol. 2018, 66, 1684–1694. [Google Scholar] [CrossRef]
- Hayreh, S.S. Acute Retinal Arterial Occlusive Disorders. Prog. Retin. Eye Res. 2011, 30, 359–394. [Google Scholar] [CrossRef]
- Varma, D.D.; Cugati, S.; Lee, A.W.; Chen, C.S. A Review of Central Retinal Artery Occlusion: Clinical Presentation and Management. Eye 2013, 27, 688–697. [Google Scholar] [CrossRef]
- Lawlor, M.; Perry, R.; Hunt, B.J.; Plant, G.T. Strokes and Vision: The Management of Ischemic Arterial Disease Affecting the Retina and Occipital Lobe. Surv. Ophthalmol. 2015, 60, 296–309. [Google Scholar] [CrossRef]
- Liang, S.; Chen, Q.; Hu, C.; Chen, M. Association of Paracentral Acute Middle Maculopathy with Visual Prognosis in Retinal Artery Occlusion: A Retrospective Cohort Study. J. Ophthalmol. 2022, 2022, 9404973. [Google Scholar] [CrossRef]
- Zhang, Z.; Jiang, Y.; Huang, X.; Wu, Z.; Ke, B. Clinical Characteristics of Paracentral Acute Middle Maculopathy in Eyes with Retinal Vascular Occlusion Diseases in Chinese Patients. J. Ophthalmol. 2021, 2021, 8867570. [Google Scholar] [CrossRef]
- Gong, H.; Wu, B.; Xie, S. Visual Acuity Assessment of Central Retinal Artery Occlusion Patients with or without Paracentral Acute Middle Maculopathy via OCT-A. BMC Ophthalmol. 2023, 23, 412. [Google Scholar] [CrossRef] [PubMed]
- Rogers, S.; McIntosh, R.L.; Cheung, N.; Lim, L.; Wang, J.J.; Mitchell, P.; Kowalski, J.W.; Nguyen, H.; Wong, T.Y. International Eye Disease Consortium The Prevalence of Retinal Vein Occlusion: Pooled Data from Population Studies from the United States, Europe, Asia, and Australia. Ophthalmology 2010, 117, 313–319.e1. [Google Scholar] [CrossRef] [PubMed]
- Klein, R.; Moss, S.E.; Meuer, S.M.; Klein, B.E.K. The 15-Year Cumulative Incidence of Retinal Vein Occlusion: The Beaver Dam Eye Study. Arch. Ophthalmol. 2008, 126, 513–518. [Google Scholar] [CrossRef] [PubMed]
- Hayreh, S.S.; Zimmerman, M.B.; Podhajsky, P. Incidence of Various Types of Retinal Vein Occlusion and Their Recurrence and Demographic Characteristics. Am. J. Ophthalmol. 1994, 117, 429–441. [Google Scholar] [CrossRef]
- Natural History and Clinical Management of Central Retinal Vein Occlusion. The Central Vein Occlusion Study Group. Arch. Ophthalmol. 1997, 115, 486–491. [Google Scholar] [CrossRef]
- Retinal Vein Occlusion and Traditional Risk Factors for Atherosclerosis—PubMed. Available online: https://pubmed.ncbi.nlm.nih.gov/18474782/ (accessed on 10 September 2024).
- Schmidt-Erfurth, U.; Garcia-Arumi, J.; Gerendas, B.S.; Midena, E.; Sivaprasad, S.; Tadayoni, R.; Wolf, S.; Loewenstein, A. Guidelines for the Management of Retinal Vein Occlusion by the European Society of Retina Specialists (EURETINA). Ophthalmologica 2019, 242, 123–162. [Google Scholar] [CrossRef]
- Nemiroff, J.; Phasukkijwatana, N.; Sarraf, D. Optical Coherence Tomography Angiography of Deep Capillary Ischemia. Dev. Ophthalmol. 2016, 56, 139–145. [Google Scholar] [CrossRef]
- Nemiroff, J.; Kuehlewein, L.; Rahimy, E.; Tsui, I.; Doshi, R.; Gaudric, A.; Gorin, M.B.; Sadda, S.; Sarraf, D. Assessing Deep Retinal Capillary Ischemia in Paracentral Acute Middle Maculopathy by Optical Coherence Tomography Angiography. Am. J. Ophthalmol. 2016, 162, 121–132.e1. [Google Scholar] [CrossRef]
- Cabral, D.; Fradinho, A.C.; Pereira, T.; Ramakrishnan, M.S.; Bacci, T.; An, D.; Tenreiro, S.; Seabra, M.C.; Balaratnasingam, C.; Freund, K.B. Macular Vascular Imaging and Connectivity Analysis Using High-Resolution Optical Coherence Tomography. Transl. Vis. Sci. Technol. 2022, 11, 2. [Google Scholar] [CrossRef]
- Freund, K.B.; Sarraf, D.; Leong, B.C.S.; Garrity, S.T.; Vupparaboina, K.K.; Dansingani, K.K. Association of Optical Coherence Tomography Angiography of Collaterals in Retinal Vein Occlusion With Major Venous Outflow Through the Deep Vascular Complex. JAMA Ophthalmol. 2018, 136, 1262–1270. [Google Scholar] [CrossRef]
- Pries, A.R.; Secomb, T.W.; Gaehtgens, P. Biophysical Aspects of Blood Flow in the Microvasculature. Cardiovasc. Res. 1996, 32, 654–667. [Google Scholar] [CrossRef]
- Cabral, D.; Bijon, J.; Vaz, M.; Naguib, M.; Sarraf, D.; Freund, K.B. Clinical Implications of Alternating Hypointense Bands on OCT Angiography in Retinal Vascular Occlusive Disease. Ophthalmol. Retin. 2024, 8, 971–980. [Google Scholar] [CrossRef] [PubMed]
- Clinical Characteristics of Paracentral Acute Middle Maculopathy in Eyes with Retinal Vascular Occlusion Diseases in Chinese Patients—PubMed. Available online: https://pubmed.ncbi.nlm.nih.gov/34239722/ (accessed on 9 September 2024).
- Chu, Y.K.; Hong, Y.T.; Byeon, S.H.; Kwon, O.W. In Vivo Detection of Acute Ischemic Damages in Retinal Arterial Occlusion with Optical Coherence Tomography: A Prominent Middle Limiting Membrane Sign. Retina 2013, 33, 2110–2117. [Google Scholar] [CrossRef] [PubMed]
- Ko, J.; Kwon, O.W.; Byeon, S.H. Optical Coherence Tomography Predicts Visual Outcome in Acute Central Retinal Vein Occlusion. Retina 2014, 34, 1132–1141. [Google Scholar] [CrossRef]
- Furashova, O.; Matthè, E. Hyperreflectivity of Inner Retinal Layers as a Quantitative Parameter of Ischemic Damage in Acute Retinal Vein Occlusion (RVO): An Optical Coherence Tomography Study. Clin. Ophthalmol. 2020, 14, 2453–2462. [Google Scholar] [CrossRef] [PubMed]
- Limoli, C.; Raja, L.D.; Wagner, S.K.; Ferraz, D.; Bolz, M.; Vujosevic, S.; Nucci, P.; Nicholson, L.; Keane, P.A.; Khalid, H.; et al. Exploring Patient Demographics and Presence of Retinal Vascular Disease in Paracentral Acute Middle Maculopathy. Am. J. Ophthalmol. 2024, 260, 182–189. [Google Scholar] [CrossRef]
- Kropp, M.; Golubnitschaja, O.; Mazurakova, A.; Koklesova, L.; Sargheini, N.; Vo, T.-T.K.S.; de Clerck, E.; Polivka, J.; Potuznik, P.; Polivka, J.; et al. Diabetic Retinopathy as the Leading Cause of Blindness and Early Predictor of Cascading Complications—Risks and Mitigation. EPMA J. 2023, 14, 21–42. [Google Scholar] [CrossRef]
- Wang, W.; Lo, A.C.Y. Diabetic Retinopathy: Pathophysiology and Treatments. Int. J. Mol. Sci. 2018, 19, 1816. [Google Scholar] [CrossRef]
- Duh, E.J.; Sun, J.K.; Stitt, A.W. Diabetic Retinopathy: Current Understanding, Mechanisms, and Treatment Strategies. JCI Insight 2017, 2, e93751. [Google Scholar] [CrossRef]
- Spaide, R.F.; Koizumi, H.; Pozzoni, M.C. Enhanced Depth Imaging Spectral-Domain Optical Coherence Tomography. Am. J. Ophthalmol. 2008, 146, 496–500. [Google Scholar] [CrossRef]
- Bonnin, S.; Mané, V.; Couturier, A.; Julien, M.; Paques, M.; Tadayoni, R.; Gaudric, A. New insight into the macular deep vascular plexus imaged by optical coherence tomography angiography. Retina 2015, 35, 2347–2352. [Google Scholar] [CrossRef] [PubMed]
- Hwang, T.S.; Zhang, M.; Bhavsar, K.; Zhang, X.; Campbell, J.P.; Lin, P.; Bailey, S.T.; Flaxel, C.J.; Lauer, A.K.; Wilson, D.J.; et al. Visualization of 3 Distinct Retinal Plexuses by Projection-Resolved Optical Coherence Tomography Angiography in Diabetic Retinopathy. JAMA Ophthalmol. 2016, 134, 1411–1419. [Google Scholar] [CrossRef] [PubMed]
- Ashraf, M.; Sampani, K.; Clermont, A.; Abu-Qamar, O.; Rhee, J.; Silva, P.S.; Aiello, L.P.; Sun, J.K. Vascular Density of Deep, Intermediate and Superficial Vascular Plexuses Are Differentially Affected by Diabetic Retinopathy Severity. Investig. Ophthalmol. Vis. Sci. 2020, 61, 53. [Google Scholar] [CrossRef]
- Bhargava, M.; Ikram, M.K.; Wong, T.Y. How Does Hypertension Affect Your Eyes? J. Hum. Hypertens. 2012, 26, 71–83. [Google Scholar] [CrossRef]
- Unger, T.; Borghi, C.; Charchar, F.; Khan, N.A.; Poulter, N.R.; Prabhakaran, D.; Ramirez, A.; Schlaich, M.; Stergiou, G.S.; Tomaszewski, M.; et al. 2020 International Society of Hypertension Global Hypertension Practice Guidelines. Hypertension 2020, 75, 1334–1357. [Google Scholar] [CrossRef] [PubMed]
- Dziedziak, J.; Zaleska-Żmijewska, A.; Szaflik, J.P.; Cudnoch-Jędrzejewska, A. Impact of Arterial Hypertension on the Eye: A Review of the Pathogenesis, Diagnostic Methods, and Treatment of Hypertensive Retinopathy. Med. Sci. Monit. 2022, 28, e935135-1–e935135-12. [Google Scholar] [CrossRef]
- Kim, H.R.; Lee, N.K.; Lee, C.S.; Byeon, S.H.; Kim, S.S.; Lee, S.W.; Kim, Y.J. Retinal Vascular Occlusion Risks in High Blood Pressure and the Benefits of Blood Pressure Control. Am. J. Ophthalmol. 2023, 250, 111–119. [Google Scholar] [CrossRef]
- Drakopoulos, M.; Hooshmand, D.; Machlab, L.A.; Bryar, P.J.; Hammond, K.J.; Mirza, R.G. Machine Teaching Allows for Rapid Development of Automated Systems for Retinal Lesion Detection From Small Image Datasets. Ophthalmic Surg. Lasers Imaging Retin. 2024, 55, 475–478. [Google Scholar] [CrossRef]

| Pathophysiological Processes in PAMM | Key Points |
|---|---|
| Hypoxia in the Intermediate Retinal Tissue | The intermediate retinal tissue, within the watershed zone, is hypoxic due to insufficient perfusion by terminal segments of choroidal and retinal vasculature. |
| Watershed Zone Vulnerability | Based on the Krogh cylinder model, tissues in watershed zones are more susceptible to hypoperfusion damage. |
| Capillary Plexus Dynamics |
|
| Structural and Microvascular Vulnerability |
|
| Intermediate Retinal Layer Susceptibility | The middle retinal layers have higher oxygen demand due to horizontal cells metabolic activity, making them prone to ischemic damage. |
| Ocular Vascular Factors | |
| Venous impairment | Retinal vein occlusion [18,35,56,57] |
| Arterial insufficiency | Incomplete central retinal artery occlusion [58] |
| Incomplete cilioretinal artery occlusion [35,59,60,61] | |
| Branch retinal artery occlusion [62,63,64,65] | |
| Reperfused central retinal artery occlusion [66] | |
| Ocular ischemia syndrome [34] | |
| Combined vascular insufficiency | Diabetic retinopathy [13,34,43,67] |
| Radiation retinopathy [68] | |
| Hypertensive retinopathy [16,34] | |
| Sickle cell retinopathy [34,69] | |
| Other Ocular Factors | |
| Ocular trauma | Orbital compression injury [34] |
| Ocular surgery complications | Post-cataract [70,71] |
| Post-vitrectomy [43,72,73] | |
| Macular pucker peeling [74] | |
| Pterygium surgery [75,76] | |
| Cosmetic iris color change laser [77] | |
| Glaucoma | Primary angle closure glaucoma [78] |
| Optic nerve disorders | Anterior arteritic ischemic optic neuropathy [79] |
| Anti-Mog positive neuritis [80,81] | |
| Congenital diseases | Foveal hypoplasia [82] |
| Primary congenital glaucoma [24] | |
| Uveitis | Intraocular tubercolosis [83] |
| Idiopathic retinitis, vasculitis, aneurysms, and neuroretinitis syndrome [84] | |
| Human immunodeficiency virus retinopathy [85] | |
| Systemic Vascular Factors | |
| Venous return impedance | Chronic obstructive pulmonary disease [54] |
| Arterial flow insufficiency | Carotid stenosis [34,86,87] |
| Ischemic cardiomyopathy [88] | |
| Cardiac arrest [89] | |
| Sickle cell disease [34,63,90] | |
| Anemia + Kikuchi-Fujimoto disease [8] | |
| Polycythemia [91] | |
| Aorthic aneurism [92] | |
| Tetralogy of Fallot [91] | |
| Other Systemic Factors | |
| Infections | Coxsackie A4 infection [93] |
| COVID-19 [45,81,82,83,84,94,95,96,97] | |
| Post-viral purtscher-like retinopathy [98,99] | |
| Congenital diseases | Neurofibromatosis Type 2 [100] |
| Immune-mediated diseases | Giant-cell arteritis [101] |
| Eosinophilic granulomatosis with polyangiitis [102] | |
| Juvenile dermatomyositis [103,104] | |
| Susac syndrome [105] | |
| Primary antiphospholipid syndrome [106,107] | |
| Livedo reticularis [62] | |
| Ulcerative colitis [108] | |
| Amyloidosis [37] | |
| Leukocytoclastic vasculitis [57] | |
| Neurological Disorders | Migraines [109,110] |
| Leukoencephalopathy [111] | |
| Idiopathic intracranial hypertension [112] | |
| Meningitis [113] | |
| Trauma | Purtscher retinopathy [34,114,115,116] |
| Blunt trauma [117] | |
| Iatrogenic Factors | |
| Surgery | Aortic aneurism repair [118] |
| Cardiac catheterization [119] | |
| Cardiopulmonary bypass [55] | |
| Cosmetic filler injections [120,121] | |
| Embolic events after septoplasty [122] | |
| Endovascular embolization [123] | |
| Medications | Caffeine consumption [8] |
| Oral contraceptives [34,124] | |
| PDE-5 inhibitors [61,125] | |
| Pembrolizumab [126] | |
| Synephrine [29] | |
| Sumatriptan [8,127] | |
| Vaccinations | H1N1 vaccination [34] |
| Hepatitis B vaccination [128] | |
| COVID-19 vaccination [129] | |
| Idiopathic | |
| In otherwise healthy individuals [42] | |
| Pregnancy [130] |
Disclaimer/Publisher’s Note: The statements, opinions and data contained in all publications are solely those of the individual author(s) and contributor(s) and not of MDPI and/or the editor(s). MDPI and/or the editor(s) disclaim responsibility for any injury to people or property resulting from any ideas, methods, instructions or products referred to in the content. |
© 2025 by the authors. Licensee MDPI, Basel, Switzerland. This article is an open access article distributed under the terms and conditions of the Creative Commons Attribution (CC BY) license (https://creativecommons.org/licenses/by/4.0/).
Share and Cite
Fumi, D.; Ruggeri, F.; Fasciolo, D.; Antonello, E.; Burtini, G.; Abdolrahimzadeh, S. Paracentral Acute Middle Maculopathy (PAMM) in Ocular Vascular Diseases—What We Know and Future Perspectives. Vision 2025, 9, 19. https://doi.org/10.3390/vision9010019
Fumi D, Ruggeri F, Fasciolo D, Antonello E, Burtini G, Abdolrahimzadeh S. Paracentral Acute Middle Maculopathy (PAMM) in Ocular Vascular Diseases—What We Know and Future Perspectives. Vision. 2025; 9(1):19. https://doi.org/10.3390/vision9010019
Chicago/Turabian StyleFumi, Daniele, Francesco Ruggeri, Davide Fasciolo, Elettra Antonello, Giammarco Burtini, and Solmaz Abdolrahimzadeh. 2025. "Paracentral Acute Middle Maculopathy (PAMM) in Ocular Vascular Diseases—What We Know and Future Perspectives" Vision 9, no. 1: 19. https://doi.org/10.3390/vision9010019
APA StyleFumi, D., Ruggeri, F., Fasciolo, D., Antonello, E., Burtini, G., & Abdolrahimzadeh, S. (2025). Paracentral Acute Middle Maculopathy (PAMM) in Ocular Vascular Diseases—What We Know and Future Perspectives. Vision, 9(1), 19. https://doi.org/10.3390/vision9010019

